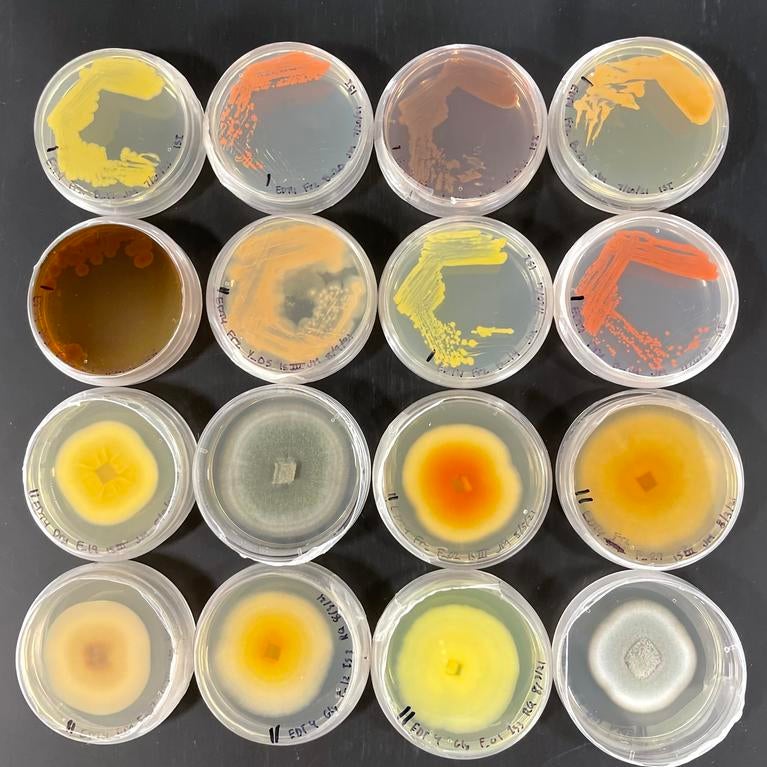
petrie dishes

64fd.jpg?h=10d202d3&itok=Qy4S-3pM)
New vaccine design uses immunity against influenza to offer faster protection against emerging pathogens
Strategy developed by UC Riverside-led research team speeds up production of antibodies against COVID-19
By Iqbal Pittalwala |
| Health












133f.jpg?h=5fd1f310&itok=iCxUHye1)


%5b42%5d%20copy585c.jpg?h=daa23bdd&itok=Df3KK2rl)